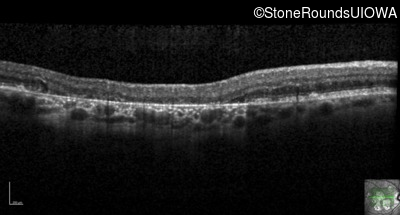
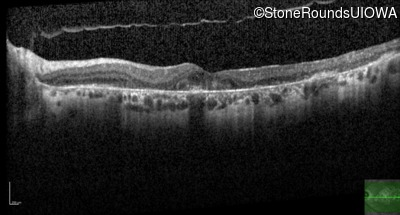
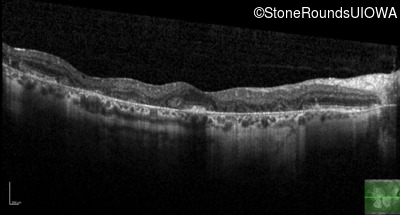
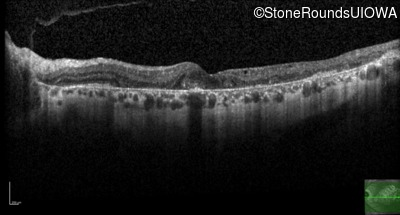
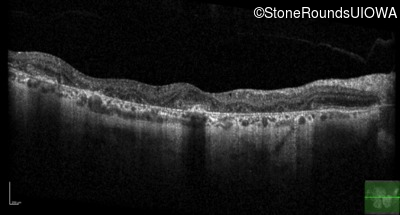
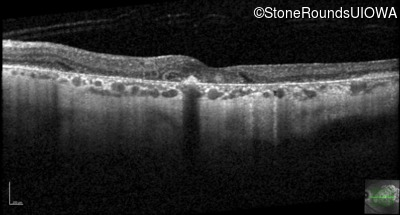
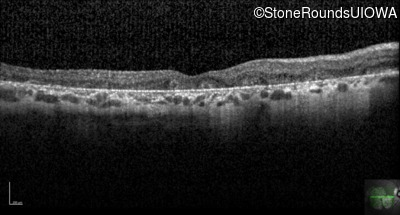
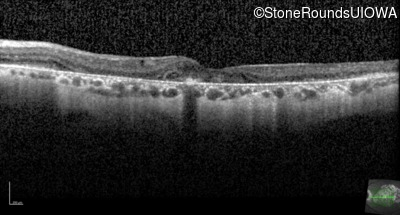

Case
SR493
Student Mode
AR Stargardt Disease (IIA)
Male
Male
Hidden
SR493
Student Mode
AR Stargardt Disease (IIA)
Male
Male
History
This 59 year old man has noticed some blank spots near the center of his vision over the last 2 years.
| Age at visit: 59 years |
| Age at visit: 60 years |
| Age at visit: 62 years |
Diagnosis & molecular findings
| Disease | Gene | Allele 1 variant(s) | Allele 2 variant(s) | Inheritance mode |
|---|---|---|---|---|
| AR Stargardt Disease | ABCA4 | Leu2027Phe CTC>TTC | IVS30+1321 A>G | AR |
Disease:
Gene:
Allele 1:
Leu2027Phe CTC>TTC
Allele 2:
IVS30+1321 A>G
Inheritance:
AR